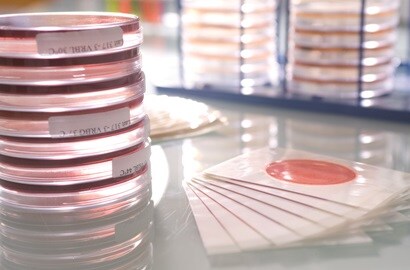
3M Petrifilm™ Plates

-
Keeping our food supply safe!
Keeping our food supply safe!-
We live in a global economy with a complex food supply chain. Food is grown, processed, packaged and transported across numerous locations before it reaches us in the grocery store. As consumers, we trust all of these steps have been completed with the highest levels of quality and safety.
To help food and beverage manufacturers ensure product quality and support the fight against food-borne illnesses, 3M developed fast, accurate microbial tests that also offer a sustainability advantage over current test methods. 3M Petrifilm Plates identify bacteria in food and beverage products that allow food producers to identify potential quality and safety issues before they become a problem.
Perhaps even more impressive are 3M Petrifilm’s environmental benefits. Compared to traditional agar methods of testing, our tests use 75% less energy, 80% less water and produce 75% less greenhouse gases as a result. They also offer users a 66% reduction in waste.
This positive sustainability impact is the result of innovation and design. 3M Petrifilm Plates provide simplified and reliable microbial indicator test results. In addition to the environmental benefits, 3M Petrifilm Plate users also find an average 80% increase in technician efficiency.
Food safety is a complex effort. Our innovation makes it easier to test across the many facets of global food production so quality, safe food can be more safely and sustainably provided for all consumers.
-

